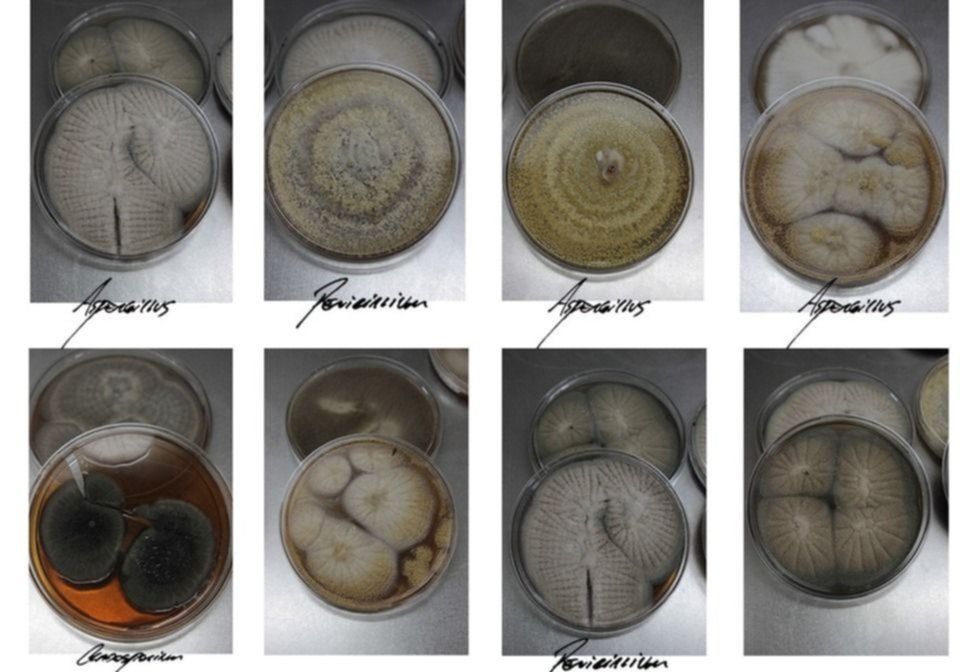

La Editorial de la UNLP (EDULP) lanzó la publicación del libro “Fungi”, una colección de imágenes que refleja de qué modo la implacable acción de los hongos puede transformarse en un hecho artístico y de valor científico. El escrito nació luego de que un grupo de profesionales de la casa de altos estudios halló cientos de antiguas placas fotográficas arruinadas y las convirtió en verdaderas obras de arte.
La aventura comenzó con el descubrimiento de alrededor de 700 diapositivas enmohecidas y deterioradas, olvidadas en interior de un bebedero de caballos, en el viejo hospital escuela de la Facultad de Ciencias Veterinarias. Fue así que la naturaleza se abrió paso y la acción de distintos fungis transformó dramáticamente aquellas imágenes fotográficas. Luego de un minucioso trabajo que demandó más de 3 años, aquellas fotos rescatadas de la voracidad de los hongos, alimentan hoy las páginas de un libro cuya riqueza visual resulta tan atrapante como original.
En “Fungi” convergen las miradas de la archivística, de las ciencias veterinarias y micológicas, y de las prácticas artísticas. El grupo de trabajo abocado a este desarrollo está encabezado por el artista plástico y audiovisual, Darian Witon; la Licenciada en Filosofía y fotógrafa, Angela Tettamanti; la Microbióloga Médica Veterinaria y Docente, Romina Della Vedova; y la Bióloga y Docente, de la Facultad de Ciencias Veterinarias, Verónica Amor.
“El libro materializa el trabajo de rastreo, recuperación y selección de un cúmulo de fotografías que, enmohecidas y deterioradas, dieron lugar a nuevas imágenes como consecuencia de la intervención de distinta clase de hongos. Ellas son un retrato en movimiento del tiempo, una imagen vacilante, ya que representan la captura momentánea de una figura que, como todo proceso biológico, continúa mutando”, reflexionó Angela Tettamanti, fotógrafa y una las autoras de la publicación.
Darian Witon, artista plástico autor del libro y trabajador no docente de la facultad, remarcó que “las ciencias veterinarias y biológicas fueron anfitrionas de la experimentación y búsqueda en las imágenes sobre las que los fungis se sentaron -literalmente- a comer”.

“Intervenido a partir de un proceso tan básico de cualquier organismo vivo, trastocaron las fotografías y la objetividad de su representación”, destacó Witon al tiempo que afirmó: “Donde la ciencia antes halló certezas y registros, hoy encontramos el misterio de lo amorfo, la incomodidad de la no figuración y la picazón de encontrarle un sentido a estos recuerdos fuera de quicio”.
Sobre la apasionante historia de este proceso creativo, el artista recordó: “lo primero que apareció fue una caja de viejas diapositivas, eran fotografías de placas de vidrio de las antiguas que se hacían con cámara de fuelle numeradas, pero discontinuas. Esa fue la punta del ovillo que nos hizo preguntarnos dónde estaba el resto. Posteriormente, pudimos dar con un buen número de placas fotográficas en un box de caballos del Viejo Hospital Escuela; que había sido destinado como depósito luego de la mudanza al Nuevo Hospital Escuela. Allí, literalmente flotando en un bebedero de caballos, se hallaban un par de estas maletas repletas de diapositivas y, en una caja aparte, un gran número de placas fotográficas con sus correspondientes sobres numerados, de los cuales sólo unos pocos contaban con alguna referencia muy escueta”.
“En una primera instancia, nos abocamos junto con mi compañero, Oscar Lalanne, a la limpieza y catalogación de estos sobres, mientras dejábamos secar el resto de las diapositivas mojadas, para luego hacer una digitalización exhaustiva de cada fotografía (placa fotográfica o diapositiva). En total fueron unas setecientas imágenes aproximadamente. En varios casos hubo que rearmar, como si fuese un rompecabezas, las placas de vidrio rotas, en otros casos esta labor fue imposible por el faltante de piezas. Una vez finalizado el trabajo de digitalización, se continuó con el escaneo de algunos rollos fílmicos que también se hallaron en estas cajas. Muchos de ellos avinagrados y muy deteriorados por la humedad, otros sobrevivían a duras penas puesto que el plegado circular de estos rollos afectaba a todo el largo del carrete”.

En ese sentido detalló: “Paralelo a este trabajo de digitalización y escaneo se llevaron algunas muestras de estas diapositivas a hisopar en la cátedra de Micología Médica e Industrial, donde fui recibido por la médica veterinaria Romina Della Vedova y la licenciada en biología Verónica Amor, ambas docentes e investigadoras de la Facultad, se abocaron al estudio de las muestras Fungi”, detalló el artista plástico.
Y agregó: “La idea de armar un libro fue la mejor forma que encontramos de nuclear y organizar este material y narrar todo el proceso de trabajo. Donde una de las cuestiones más relevantes de este proyecto es el trabajo interdisciplinario de distintas ramas donde se combina la ciencia y el arte. Algo para destacar de este proceso es que más allá del resultado artístico hay toda una información micológica que es de utilidad para la cátedra de micología. ”
Para finalizar el artista concluyó: “Debido al tiempo que pasó, estos materiales encontrados en la basura no tenían ya relevancia científica. Tampoco era posible darles uso académico, porque los cambios en los contenidos de aprendizaje y en las tecnologías para la enseñanza los hicieron obsoletos. Por eso, la reconfiguración del sentido le da un nuevo valor al pasado con este proyecto interdisciplinario”.
Los interesados pueden descargar Fungi en forma gratuita en https://www.editorial.unlp.edu.ar/industrias_culturales/fungi-20371